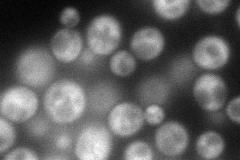
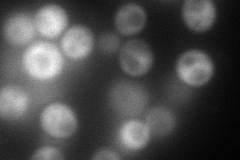
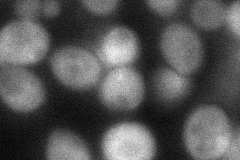
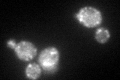
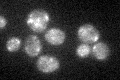

View description
Auxilin-like protein involved in vesicular transport; clathrin-binding protein required for uncoating of clathrin-coated vesicles
Localization:
Intensity:
Fold change:
Significance:
-
C’ GFP library in SD

ambiguous30.25 -
N' NOP1pr-GFP in SD
cytosol115.972 -
N' TEF2pr-mCherry in SD
cytosol125.712 -
N' NATIVEpr-GFP in SD

cytosol29.3118 -
N' TEF2pr-VC and Cyto-VN in SD
cytosol51.5182 -
C’ GFP library in SD+DTT
ambiguous54.771.81Yes -
C’ GFP library in SD+H2O2

ambiguous37.21.22No -
C’ GFP library in Starvation Media
ambiguous31.011.02No -
C’ GFP library on the background of Pup2-DaMP

ambiguous -
C’ GFP library on the background of CCT mutant

ambiguous33.94861.122No
